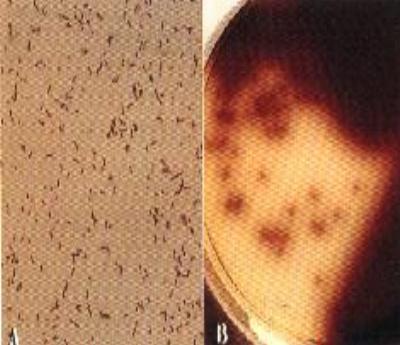

乳用山羊李斯特氏菌病
- 內容
一、病歷:
本縣某一乳用山羊場,飼養母乳羊約80餘頭,公乳羊約30~40頭、2~3月齡乳
仔羊20頭。該畜主於84年12月1日發現1頭2~3月齡乳仔羊精神萎糜,體溫40℃
、食慾減退、流涎及出現結膜炎、左臉麻痺;患畜不喜運動,強迫其步行即出現順時鐘方向
之迴旋運動,繼之斜躺,呈現歪頭斜頸等症狀,雖使用 Procaine、 Penicillin G及Dexamethasone
治療,但皆無效 。故於84年12月11日本所派員至該場瞭解疫情並帶回該頭病仔羊予
以剖檢診斷。
二、剖檢病變:
1. 外觀:消瘦,被毛無光澤、歪頭斜頸、避忌運動、患畜強迫步行則呈順時鐘方向作迴
旋運動(圖 1)。
2. 腦及其他臟器:無肉眼可見病變。
三、組織病變:
1. 腦幹實質有瀰漫性單核炎症細胞浸潤,局部呈液化壞死,其血管周圍有數層淋巴球及
組織球為主的單核炎症細胞浸潤之圍管現象(Perivascular cuffing)(圖 2)。
2. 腦幹實質有神經膠質細胞增生(microgliosis)及神經原細胞變性。
3. 小腦白質部局部輕度圍管現象,以淋巴球及組織球浸潤為主。
4. 大腦腦膜下有少量淋巴球為主的單核炎症細胞浸潤。
四、實驗室檢驗:
1. 採取病仔羊之延腦直接塗抹,再以革蘭氏染色鏡檢見陽性短桿菌。
2. 採取發病瀕死仔羊之橋腦、延腦,使用 Brain Heart Infusion Broth(Difco)當為 10 倍
乳劑調製之液體置於4℃ 冰箱中冷藏增菌(Cold enrichment),在增菌期間每週釣菌
一次並培養於 McBride Listeria Agar(Difco)上(含 5%綿羊血);經24小時培養可
見灰白色圓形且狹窄β溶血之小菌落,經革蘭氏染色鏡檢可見陽性短桿菌(圖 3A)。
3. 上述培養基發育之β溶血小菌落,再繼代培養於 Oxford Medium Base(1 liter add 10ml
rehydrated bacto modified oxford antimicrobic supplement)(Difco),經24小時培養可
見發育菌落周邊呈現黑環帶(圖 3B)。
4. 將經純化的菌體穿刺接種於 Motility Test Medium(Difco)上;經25℃培 養24~48小時
,可見傘狀運動現象(圖 4A)。
5. 動物接種試驗:Anton試驗
(1)以無菌棉棒沾取24小時培養後之 Brain Heart Infusion Broth 增菌液(10^6CFU/ml),
塗抹於小兔及天竺鼠之眼結膜上,經 24~48小時,兔 子及天竺鼠產生化膿性結膜
炎(圖 4B)。
(2)將兔子及天竺鼠之結膜炎分泌物培養於McBride Listeria Agar(含5% 綿羊血)上,
經24小時37℃培養亦分離出L. monocytogenes。
五、診 斷:
李斯特氏菌病(Listeriosis)
六、討論及參考文獻:
(一)討論
1. 本病是由 Listeria monocytogenes 感染所引起之高度致死性人畜共通傳染病,在公共衛生
上為不可忽視之重要疾病。由於本菌廣泛分佈於自然界中,故可生存於人體、畜禽、野
生動物、馬蠅、蝨、壁蝨、土壤、肥料、污水、腐蝕植物之莖葉、青貯料、畜產品、海
產、蔬果等生物;據文獻記載,對人畜之威脅最大,可造成病害;因以經口感染為原則
,所以必需著重食品衛生及家畜禽之飼料衛生管理,以防止本病發生。
2. 由文獻記載,被本菌感染而顯現臨床症狀,可分為:
(a) 腦炎型:顯現中樞神經系統障礙。
(b) 胃腸敗血症型:引起肺、肝、脾及心肌等內臟器官之充出血。
(c) 胎盤炎型:主要引起懷孕母羊流產。
一般反芻動物被 L. monocytogenes 感染而引起之症狀以腦炎為主症,單胃動物及鳥
類則引起敗血症。至於感染人可引起小孩和老人之腦脊髓膜炎;同時亦可引起幼兒之敗
血症及孕婦胎盤感染導致流產。
3. 血液檢查,牛、羊等草食動物不會有單核球增多現象,而兔、齧齒類動物則有單核球增
多症狀。
4. 本菌的致病途徑仍不清楚,最可能的方式有:
(1) 羊餵飼硬纖維質飼料及摻合釘、金屬等食物時,經常在口粘膜造成擦破及刺傷性小
傷口(不明顯的微細傷口),病原菌(特別在食物中)由口粘膜的傷口侵入口粘膜
下之神經系(主為三叉神經)的神經鞘而順次上行到延腦等中樞神經系統而致病。
(2) 病菌由消化道進入血液,經循環而形成敗血症。
(3) 病菌平常潛伏於動物體內,當環境或生理狀況改變時,病原體大量增殖而致病。
故上述三點,對於本病之致病途徑,實有待進一步之探討。
(二)參考文獻:
1. 李崇道。1982,獸醫病理學,黎明文化事業股份有限公司,P.873-874。
2. .劉榮標。1984,獸醫微生物學上冊,藝軒圖書出版社,P.311-321。
3. 蔡文城。1993,實用臨床微生物診斷學第七版,眾光文化事業有限公司, P.470-474。
4. 歐文華。1986,羊病指南第二版,畜牧半月刊社,P.68-69。
5. 張登欽。1984,臨床豬病學(李氏菌病),華香園出版社,P.470-476。
6. 潘銘正。1994,獸醫臨床細菌學檢驗手冊(單核球增生李氏菌),台灣養豬 科學研究所
,P75-81。7. 吳永惠。1989,牛病學第一版,藝軒圖書出版社,P.191-193。
8. 林達雄。1984,人畜共通傳染病(9),動物醫學第33期,P.62-63。
9. 鄭成昌、陳錦章。1987,豬李氏菌病,動物醫學第48期,P.2-3。
10. 經濟部中央標準局。1992,食品微生物檢驗方法-李斯特菌之檢驗,5 月, CNS 12982,N6238。
11. Carter,G.R. Listeria and Erysipelothrix, In "Diagnostic Procedures in Veterinary Bacteriology and
Mycology", 5th ed, G.R.Carter and J.R. Cole, Jr., 1990. Academic Press, Inc. P.253-259.
12. Quinn, P.J., M.E. Carter, B.Markey, and G.R.Carter. 1994. Listeria species, In "Clinical Veterinary
Microbiology", P.J.Quinn et al. ed. 1994. Wolfe Publishing, an imprint of Mosby. P.170-174.
13. Smith, M.C. and D.M. Sherman. Nervous System, In "Goat Medicine", C.C.Cann, 1994. Lea &
Febiger, P.141-144.


圖 1:2~3月齡乳用山羊,外觀呈消瘦、被毛無光澤、 圖 2:腦幹、腦部實質組織血管周圍呈現圍管現象,
歪頭斜頸。 由數層淋巴球及組織球浸潤,H&E stain 400X

圖3A:培養於 McBride Listeria 上,經24小時發育, 圖 4A:將經純化的分離菌體,接種於Motility Test
經革蘭氏染色,呈現陽性短桿菌,1000X。 Medium內經24~48小時呈現典型傘形運動
圖3B:將分離菌體培養於 Oxford medium base,經 性狀。
24小時發育,可見發育菌落周邊呈現黑色環 圖4B:將培養分離鑑定L. monocytogenes 菌體,塗
帶變化。 抹於兔子眼結膜上,經24~48小時,外觀呈
現化膿性眼結膜炎。
